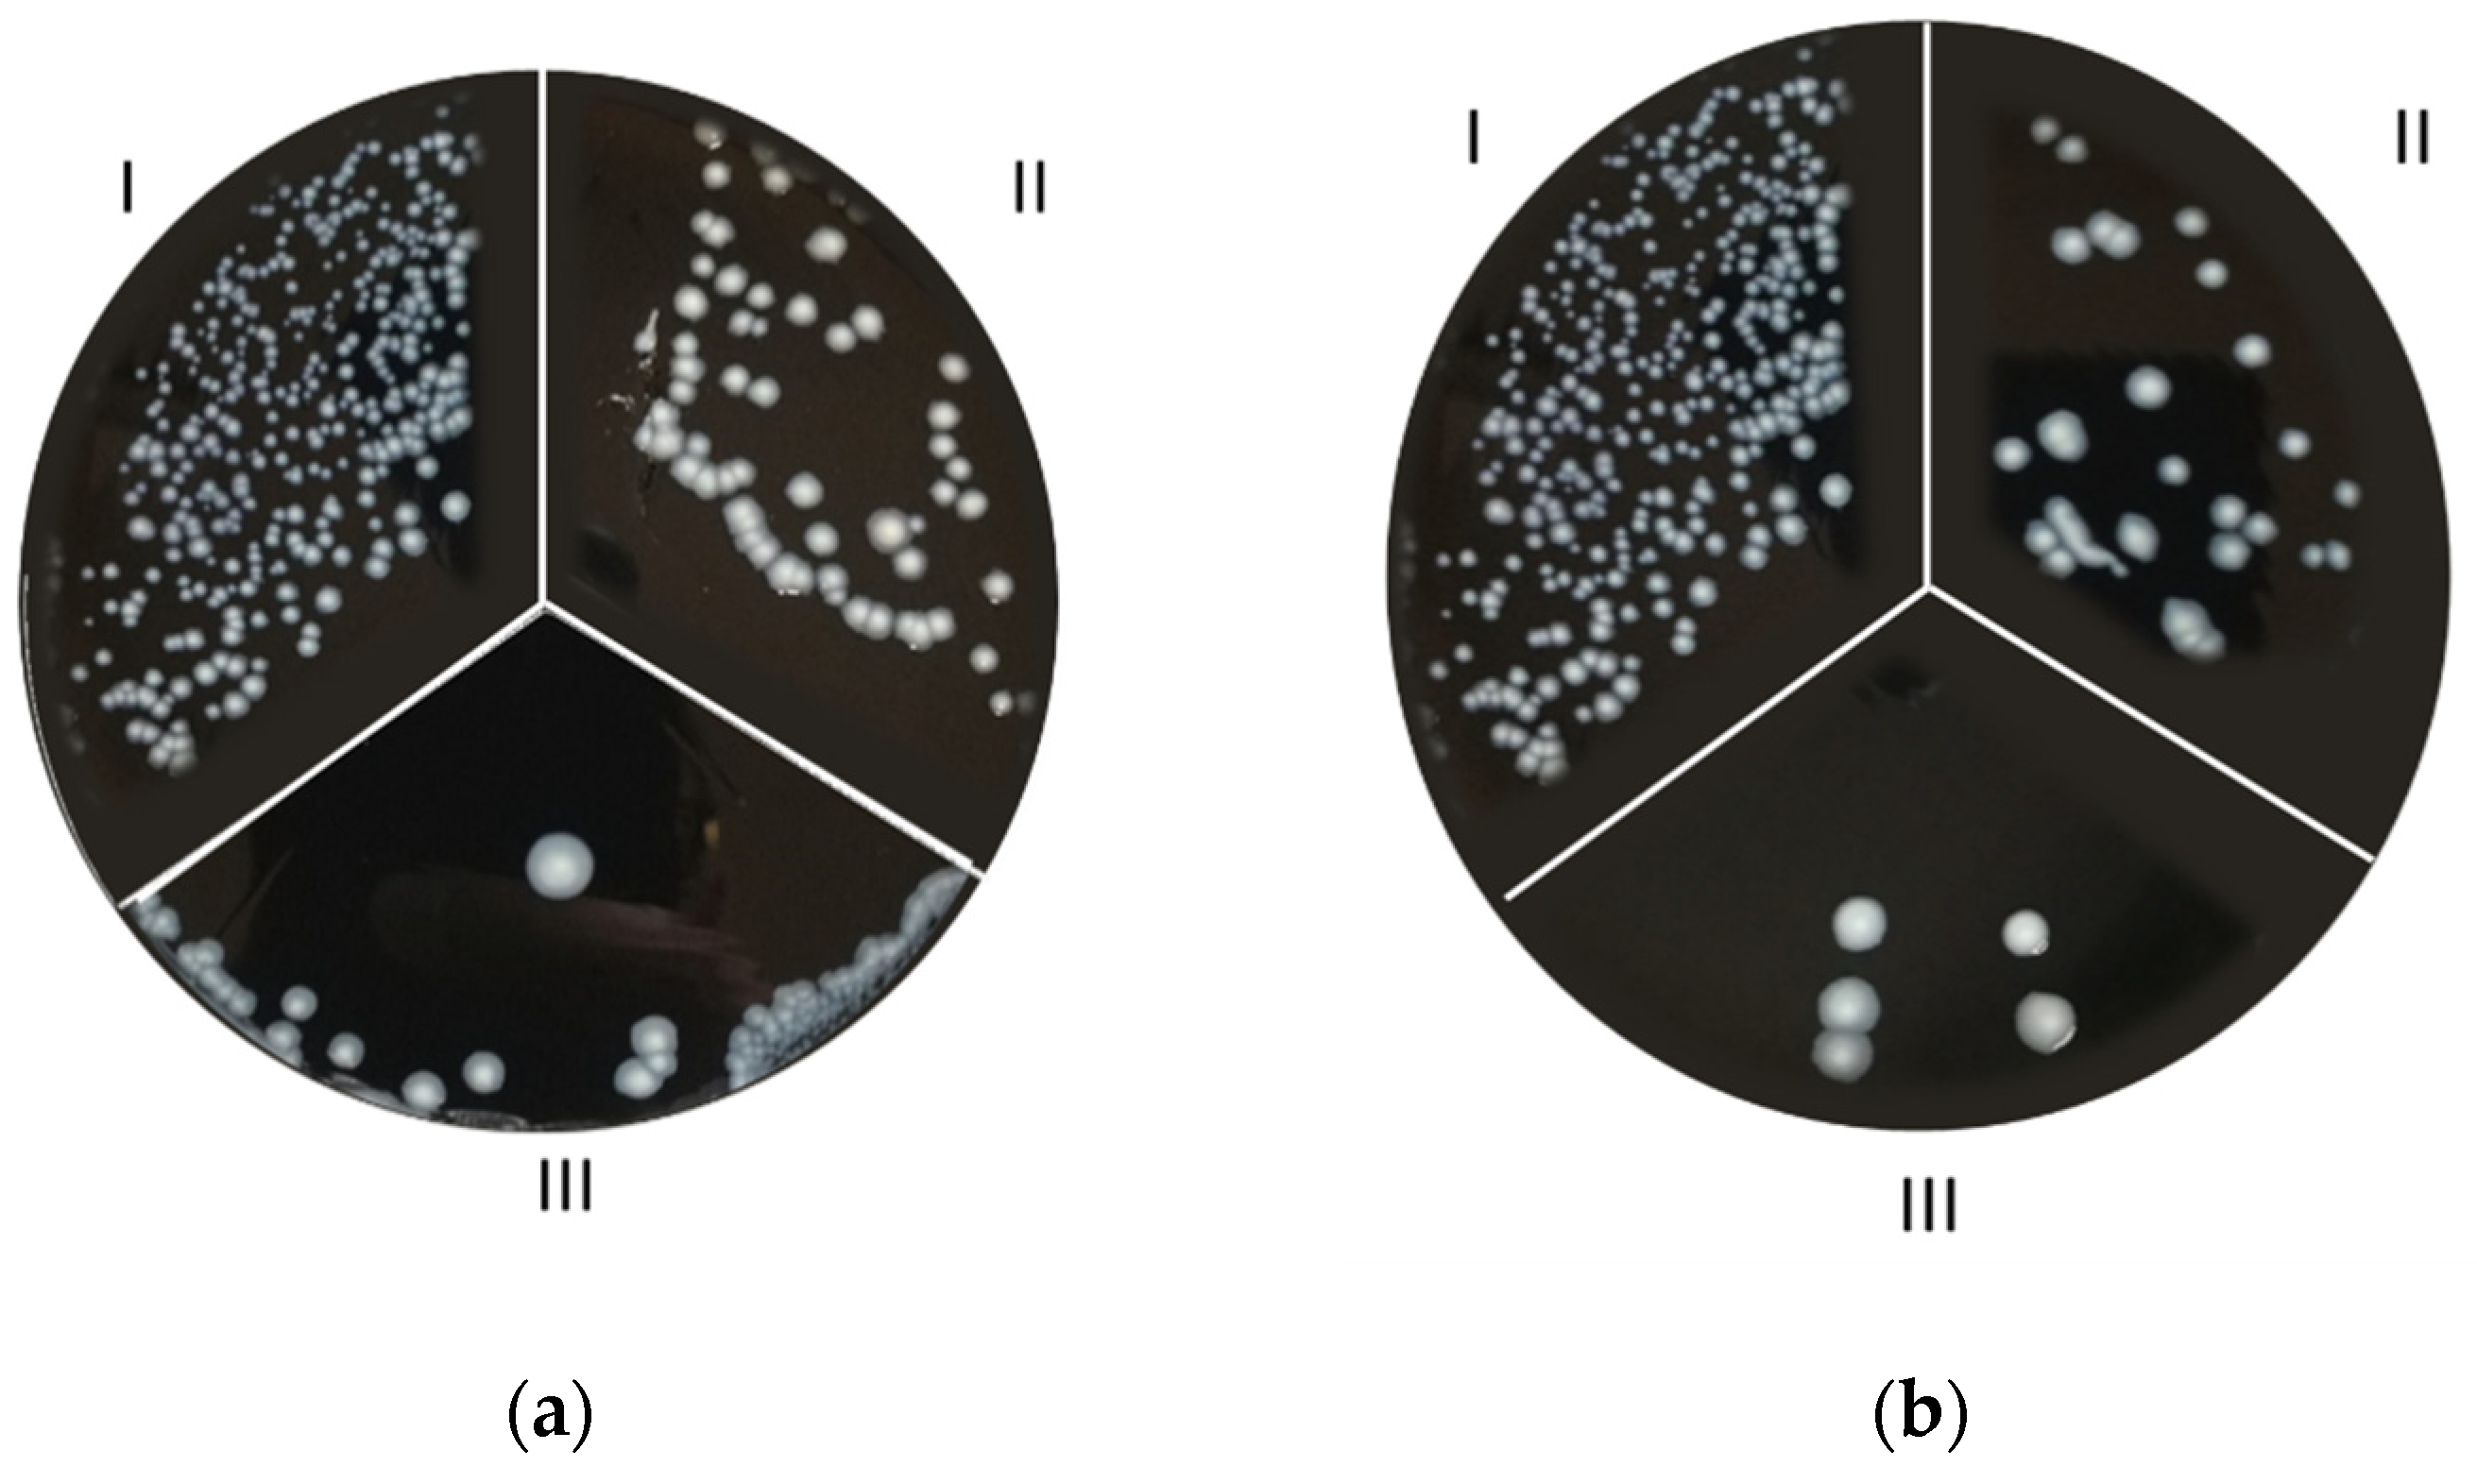
Microorganisms 10 00870 g005a Microorganisms 10 00870 g005a
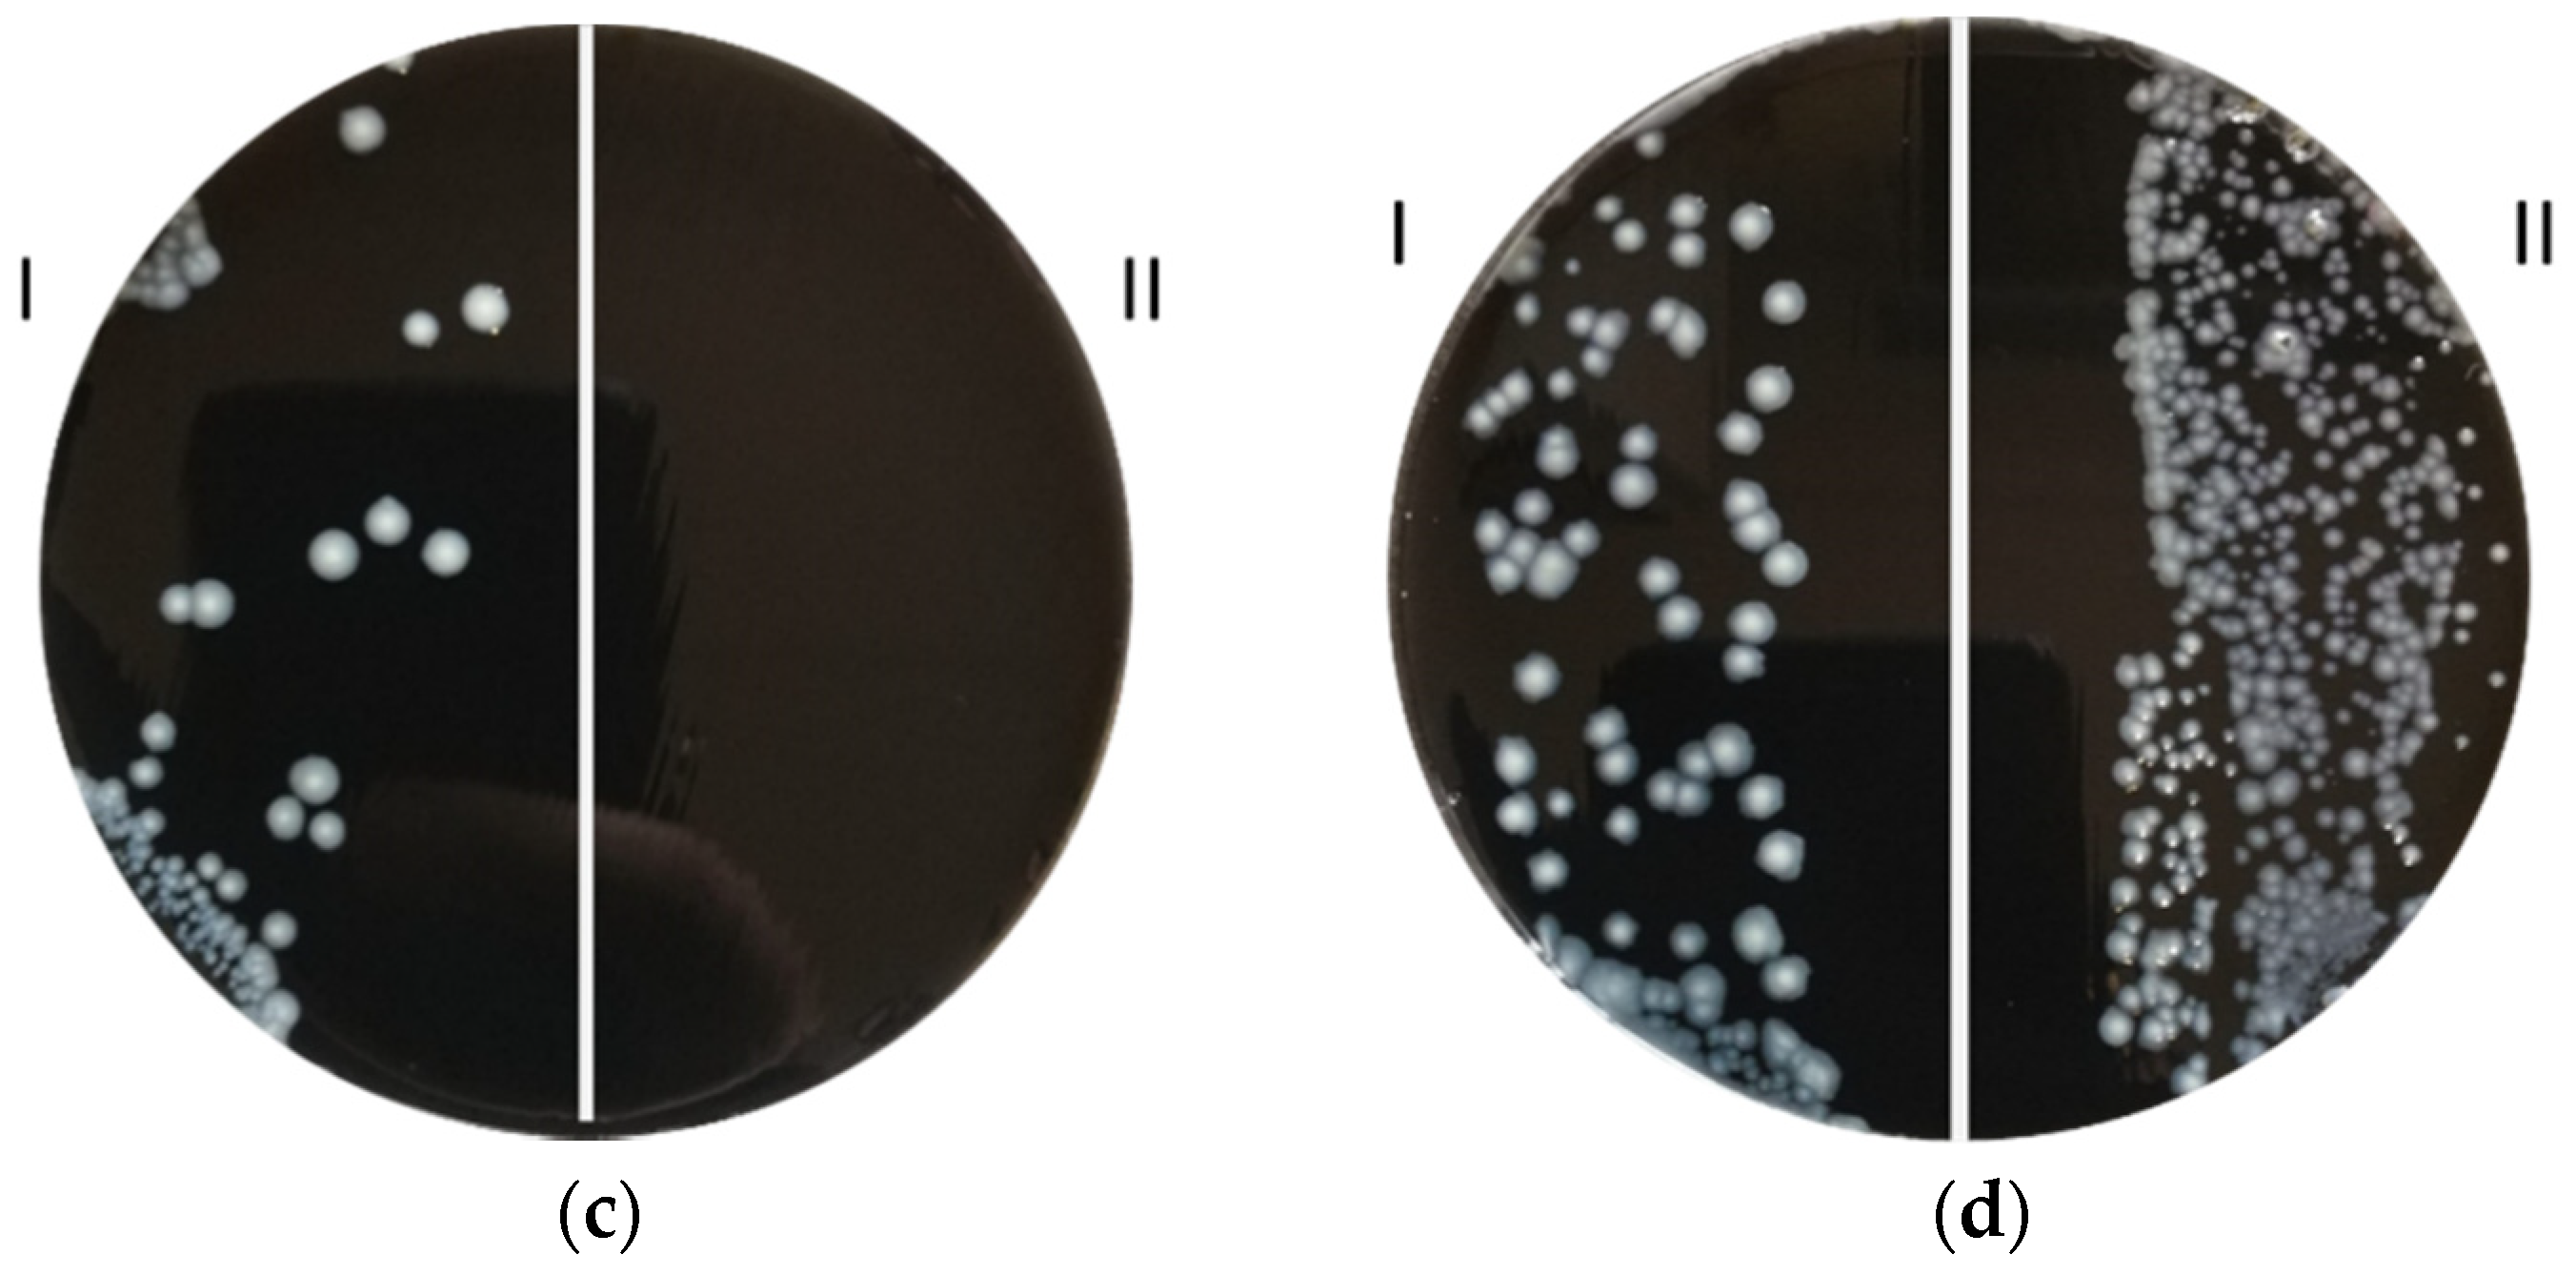
Microorganisms 10 00870 g005b Microorganisms 10 00870 g005b

Innovative Antibiofilm Smart Surface against Legionella for Water Systems
Abstract
1. Introduction
2. Materials and Methods
2.1. Chemicals
2.2. Zone of Inhibition Test: Coupons and L. pneumophila Culture Preparation
2.3. Biofilm Formation Test: Sample Preparation
2.4. Biofilm Formation Test: Sample Analysis
2.5. PH Measurements
2.6. Filter Coating Test: Sample Preparation
3. Results
4. Conclusions
Author Contributions
Funding
Data Availability Statement
Conflicts of Interest
References
- Herwaldt, L.A.; Marra, A.R. Legionella: A Reemerging Pathogen. Curr. Opin. Infect. Dis. 2018, 31, 325–333. [Google Scholar] [CrossRef] [PubMed]
- Coniglio, M.A.; Ferrante, M.; Yassin, M.H. Preventing Healthcare-Associated Legionellosis: Results after 3 Years of Continuous Disinfection of Hot Water with Monochloramine and an Effective Water Safety Plan. Int. J. Environ. Res. Public Health 2018, 15, 1594. [Google Scholar] [CrossRef] [PubMed]
- Committee on Management of Legionella in Water Systems; Water Science and Technology Board; Board on Life Sciences; Board on Population Health and Public Health Practice; Division on Earth and Life Studies; Health and Medicine Division; National Academies of Sciences, Engineering, and Medicine. Management of Legionella in Water Systems; National Academies Press: Washington, DC, USA, 2019; p. 25474. ISBN 978-0-309-49382-6. [Google Scholar]
- Donlan, R.M. Biofilms: Microbial Life on Surfaces. Emerg. Infect. Dis. 2002, 8, 881–890. [Google Scholar] [CrossRef] [PubMed]
- Butler, C.S.; Boltz, J.P. 3.6—Biofilm Processes and Control in Water and Wastewater Treatment. In Comprehensive Water Quality and Purification; Ahuja, S., Ed.; Elsevier: Waltham, MA, USA, 2014; pp. 90–107. ISBN 978-0-12-382183-6. [Google Scholar]
- Wright, J.B.; Ruseska, I.; Costerton, J.W. Decreased Biocide Susceptibility of Adherent Legionella Pneumophila. J. Appl. Bacteriol. 1991, 71, 531–538. [Google Scholar] [CrossRef]
- Lin, Y.E.; Stout, J.E.; Yu, V.L. Controlling Legionella in Hospital Drinking Water: An Evidence-Based Review of Disinfection Methods. Infect. Control Hosp. Epidemiol. 2011, 32, 166–173. [Google Scholar] [CrossRef]
- Sehar, S.; Naz, I. Role of the Biofilms in Wastewater Treatment; IntechOpen: London, UK, 2016; ISBN 978-953-51-2436-8. [Google Scholar]
- Naz, I.; Hodgson, D.; Smith, A.; Marchesi, J.; Ahmed, S.; Avignone-Rossa, C.; Saroj, D.P. Effect of the Chemical Composition of Filter Media on the Microbial Community in Wastewater Biofilms at Different Temperatures. RSC Adv. 2016, 6, 104345–104353. [Google Scholar] [CrossRef]
- Sciuto, E.L.; Laganà, P.; Filice, S.; Scalese, S.; Libertino, S.; Corso, D.; Faro, G.; Coniglio, M.A. Environmental Management of Legionella in Domestic Water Systems: Consolidated and Innovative Approaches for Disinfection Methods and Risk Assessment. Microorganisms 2021, 9, 577. [Google Scholar] [CrossRef]
- Srivastav, A.L.; Patel, N.; Chaudhary, V.K. Disinfection By-Products in Drinking Water: Occurrence, Toxicity and Abatement. Environ. Pollut. 2020, 267, 115474. [Google Scholar] [CrossRef]
- Balaure, P.C.; Grumezescu, A.M. Recent Advances in Surface Nanoengineering for Biofilm Prevention and Control. Part II: Active, Combined Active and Passive, and Smart Bacteria-Responsive Antibiofilm Nanocoatings. Nanomaterials 2020, 10, 1527. [Google Scholar] [CrossRef]
- Amjad, Z. Reverse Osmosis: Membrane Technology, Water Chemistry, and Industrial Applications; Van Nostrand Reinhold: New York, NY, USA, 1993; ISBN 978-0-442-23964-0. [Google Scholar]
- Nurioglu, A.G.; Esteves, A.C.C.; With, G. de Non-Toxic, Non-Biocide-Release Antifouling Coatings Based on Molecular Structure Design for Marine Applications. J. Mater. Chem. B 2015, 3, 6547–6570. [Google Scholar] [CrossRef]
- Parkinson, J.; Baron, J.L.; Hall, B.; Bos, H.; Racine, P.; Wagener, M.M.; Stout, J.E. Point-of-Use Filters for Prevention of Health Care–Acquired Legionnaires’ Disease: Field Evaluation of a New Filter Product and Literature Review. Am. J. Infect. Control 2020, 48, 132–138. [Google Scholar] [CrossRef] [PubMed]
- Oyanedel-Craver, V.A.; Smith, J.A. Sustainable Colloidal-Silver-Impregnated Ceramic Filter for Point-of-Use Water Treatment. Environ. Sci. Technol. 2008, 42, 927–933. [Google Scholar] [CrossRef] [PubMed]
- Li, X.; Wu, B.; Chen, H.; Nan, K.; Jin, Y.; Sun, L.; Wang, B. Recent Developments in Smart Antibacterial Surfaces to Inhibit Biofilm Formation and Bacterial Infections. J. Mater. Chem. B 2018, 6, 4274–4292. [Google Scholar] [CrossRef] [PubMed]
- Vargas-Reus, M.A.; Memarzadeh, K.; Huang, J.; Ren, G.G.; Allaker, R.P. Antimicrobial Activity of Nanoparticulate Metal Oxides against Peri-Implantitis Pathogens. Int. J. Antimicrob. Agents 2012, 40, 135–139. [Google Scholar] [CrossRef]
- Milner, S.T. Polymer Brushes. Science 1991, 251, 905–914. [Google Scholar] [CrossRef]
- Page, K.; Wilson, M.; Parkin, I.P. Antimicrobial Surfaces and Their Potential in Reducing the Role of the Inanimate Environment in the Incidence of Hospital-Acquired Infections. J. Mater. Chem. 2009, 19, 3819–3831. [Google Scholar] [CrossRef]
- Swartjes, J.J.T.M.; Sharma, P.K.; van Kooten, T.G.; van der Mei, H.C.; Mahmoudi, M.; Busscher, H.J.; Rochford, E.T.J. Current Developments in Antimicrobial Surface Coatings for Biomedical Applications. Curr. Med. Chem. 2015, 22, 2116–2129. [Google Scholar] [CrossRef]
- Campoccia, D.; Montanaro, L.; Arciola, C.R. A Review of the Biomaterials Technologies for Infection-Resistant Surfaces. Biomaterials 2013, 34, 8533–8554. [Google Scholar] [CrossRef]
- Oh, Y.; Noga, R.; Shanov, V.; Ryu, H.; Chandra, H.; Yadav, B.; Yadav, J.; Chae, S. Electrically Heatable Carbon Nanotube Point-of-Use Filters for Effective Separation and in-Situ Inactivation of Legionella Pneumophila. Chem. Eng. J. 2019, 366, 21–26. [Google Scholar] [CrossRef]
- Zhang, D. 6—Nonwovens for Consumer and Industrial Wipes. In Applications of Nonwovens in Technical Textiles; Woodhead Publishing Series in Textiles; Chapman, R.A., Ed.; Woodhead Publishing: Sawston, UK, 2010; pp. 103–119. ISBN 978-1-84569-437-1. [Google Scholar]
- Sciuto, E.L.; Filice, S.; Coniglio, M.A.; Faro, G.; Gradon, L.; Galati, C.; Spinella, N.; Libertino, S.; Scalese, S. Antimicrobial S-PBC Coatings for Innovative Multifunctional Water Filters. Molecules 2020, 25, 5196. [Google Scholar] [CrossRef]
- Filice, S.; Mazurkiewicz-Pawlicka, M.; Malolepszy, A.; Stobinski, L.; Kwiatkowski, R.; Boczkowska, A.; Gradon, L.; Scalese, S. Sulfonated Pentablock Copolymer Membranes and Graphene Oxide Addition for Efficient Removal of Metal Ions from Water. Nanomaterials 2020, 10, 1157. [Google Scholar] [CrossRef] [PubMed]
- Filice, S.; D’Angelo, D.; Scarangella, A.; Iannazzo, D.; Compagnini, G.; Scalese, S. Highly Effective and Reusable Sulfonated Pentablock Copolymer Nanocomposites for Water Purification Applications. RSC Adv. 2017, 7, 45521–45534. [Google Scholar] [CrossRef]
- D’Angelo, D.; Filice, S.; Scarangella, A.; Iannazzo, D.; Compagnini, G.; Scalese, S. Bi2O3/Nexar® Polymer Nanocomposite Membranes for Azo Dyes Removal by UV–Vis or Visible Light Irradiation. Catal. Today 2019, 321–322, 158–163. [Google Scholar] [CrossRef]
- Wadowsky, R.M.; Yee, R.B.; Mezmar, L.; Wing, E.J.; Dowling, J.N. Hot Water Systems as Sources of Legionella Pneumophila in Hospital and Nonhospital Plumbing Fixtures. Appl. Environ. Microbiol. 1982, 43, 1104–1110. [Google Scholar] [CrossRef] [PubMed]
- Habicht, W.; Müller, H.E. Occurrence and Parameters of Frequency of Legionella in Warm Water Systems of Hospitals and Hotels in Lower Saxony. Zent. Bakteriol Mikrobiol Hyg B 1988, 186, 79–88. Available online: https://pubmed.ncbi.nlm.nih.gov/3134774/ (accessed on 1 March 2022).
- Hwang, I.-Y.; Park, E.-H.; Park, Y.-K.; Park, S.-H.; Sung, G.-H.; Park, H.-Y.; Lee, Y.-C. Distribution of Legionella Pneumophila Serogroups Isolated from Water Systems of Public Facilities In Busan, South Korea. Southeast Asian J. Trop. Med. Public Health 2016, 47, 8. [Google Scholar]
- Ditommaso, S.; Giacomuzzi, M.; Rivera, S.R.A.; Raso, R.; Ferrero, P.; Zotti, C.M. Virulence of Legionella Pneumophila Strains Isolated from Hospital Water System and Healthcare-Associated Legionnaires’ Disease in Northern Italy between 2004 and 2009. BMC Infect. Dis. 2014, 14, 483. [Google Scholar] [CrossRef]
- Furugen, M.; Koide, M.; Teruya, H.; Naha, Y.; Tamayose, M.; Akamine, M.; Uchihara, T.; Atsumi, E.; Haranaga, S.; Yara, S.; et al. Legionella Pneumonia Caused by Legionella Pneumophila Serogroup 2: Second Case Report in Japan. J. Infect. Chemother. 2008, 14, 161–165. [Google Scholar] [CrossRef]
- Kawanami, T.; Yatera, K.; Fukuda, K.; Yamasaki, K.; Kunimoto, M.; Nagata, S.; Nishida, C.; Ishimoto, H.; Ogawa, M.; Taniguchi, H.; et al. Diagnosis of Fulminant Pneumonia Caused by Legionella Pneumophila Serogroup 8 with the Sequence Analysis of the 16S RRNA Gene. Tohoku J. Exp. Med. 2011, 225, 65–69. Available online: https://kyushu-u.pure.elsevier.com/en/publications/diagnosis-of-fulminant-pneumonia-caused-by-legionella-pneumophila (accessed on 1 March 2022). [CrossRef][Green Version]
- Ito, A.; Ishida, T.; Tachibana, H.; Ito, Y.; Takaiwa, T.; Fujii, H.; Hashimoto, T.; Nakajima, H.; Amemura-Maekawa, J. A Case of Community-Acquired Pneumonia Due to Legionella Pneumophila Serogroup 9 Wherein Initial Treatment with Single-Dose Oral Azithromycin Appeared Useful. Jpn. J. Infect. Dis. 2017, 70, 660–662. [Google Scholar] [CrossRef]
- Heath, C.H.; Grove, D.I.; Looke, D.F. Delay in Appropriate Therapy of Legionella Pneumonia Associated with Increased Mortality. Eur. J. Clin. Microbiol. Infect. Dis. 1996, 15, 286–290. [Google Scholar] [CrossRef] [PubMed]
- Sztuk-Sikorska, E.; Leon, G. Biofouling Reduction for Improvement of Depth Water Filtration. Filter Production and Testing. Chem. Process. Eng. 2016, 37, 319–330. [Google Scholar] [CrossRef]
- World Health Organization; International Water Association. Water Safety Plan Manual: Step-by-Step Risk Management for Drinking-Water Suppliers; World Health Organization: Geneva, Switzerland, 2009; ISBN 978-92-4-156263-8.
- Flemming, H.-C.; Percival, S.L.; Walker, J.T. Contamination Potential of Biofilms in Water Distribution Systems. Water Supply 2002, 2, 271–280. [Google Scholar] [CrossRef]
- European Centre for Disease Prevention and Control. European Technical Guidelines for the Prevention, Control and Investigation of Infections Caused by Legionella Species; European Centre for Disease Prevention and Control: Solna, Sweden, 2017. Available online: https://www.ecdc.europa.eu/en/publications-data/european-technical-guidelines-prevention-control-and-investigation-infections (accessed on 27 February 2022).
- Donlan, R.M.; Costerton, J.W. Biofilms: Survival Mechanisms of Clinically Relevant Microorganisms. Clin. Microbiol. Rev. 2002, 15, 167–193. Available online: https://journals.asm.org/doi/10.1128/CMR.15.2.167-193.2002?url_ver=Z39.88-2003&rfr_id=ori:rid:crossref.org&rfr_dat=cr_pub%20%200pubmed (accessed on 27 February 2022). [CrossRef] [PubMed]
- Berjeaud, J.-M.; Chevalier, S.; Schlusselhuber, M.; Portier, E.; Loiseau, C.; Aucher, W.; Lesouhaitier, O.; Verdon, J. Legionella Pneumophila: The Paradox of a Highly Sensitive Opportunistic Waterborne Pathogen Able to Persist in the Environment. Front. Microbiol. 2016, 7, 486. [Google Scholar] [CrossRef] [PubMed]

| Sample | T0 | 10 min | 1 h | 16 h | 48 h |
|---|---|---|---|---|---|
| H2O + PP | 8.73 | 8.80 | 8.81 | 7.48 | 7.22 |
| H2O + s-PBC@PP | 8.71 | 6.83 | 6.73 | 6.81 | 6.70 |
| dH2O + PP | 7 | 6.76 | 6.58 | 6.25 | 5.85 |
| dH2O + s-PBC@PP | 7.28 | 3.53 | 3.12 | 2.98 | 2.95 |
| Tryptose broth + s-PBC@PP | 6.70 | 6.50 | 6.45 | 6.73 | 6.75 |
| L. pneumophila + s-PBC@PP | 6.71 | 6.42 | 6.37 | 6.00 | 6.66 |
| L. pneumophila + PP * | 6.72 | N.D. | N.D. | 5.86 | N.D. |
| L. pneumophila + s-PBC@PP * | 6.71 | N.D. | N.D. | 6.78 | N.D. |
Publisher’s Note: MDPI stays neutral with regard to jurisdictional claims in published maps and institutional affiliations. |
© 2022 by the authors. Licensee MDPI, Basel, Switzerland. This article is an open access article distributed under the terms and conditions of the Creative Commons Attribution (CC BY) license (https://creativecommons.org/licenses/by/4.0/).
Share and Cite
Filice, S.; Sciuto, E.L.; Scalese, S.; Faro, G.; Libertino, S.; Corso, D.; Timpanaro, R.M.; Laganà, P.; Coniglio, M.A. Innovative Antibiofilm Smart Surface against Legionella for Water Systems. Microorganisms 2022, 10, 870. https://doi.org/10.3390/microorganisms10050870
Filice S, Sciuto EL, Scalese S, Faro G, Libertino S, Corso D, Timpanaro RM, Laganà P, Coniglio MA. Innovative Antibiofilm Smart Surface against Legionella for Water Systems. Microorganisms. 2022; 10(5):870. https://doi.org/10.3390/microorganisms10050870
Chicago/Turabian StyleFilice, Simona, Emanuele Luigi Sciuto, Silvia Scalese, Giuseppina Faro, Sebania Libertino, Domenico Corso, Rosario Manuel Timpanaro, Pasqualina Laganà, and Maria Anna Coniglio. 2022. "Innovative Antibiofilm Smart Surface against Legionella for Water Systems" Microorganisms 10, no. 5: 870. https://doi.org/10.3390/microorganisms10050870
APA StyleFilice, S., Sciuto, E. L., Scalese, S., Faro, G., Libertino, S., Corso, D., Timpanaro, R. M., Laganà, P., & Coniglio, M. A. (2022). Innovative Antibiofilm Smart Surface against Legionella for Water Systems. Microorganisms, 10(5), 870. https://doi.org/10.3390/microorganisms10050870

